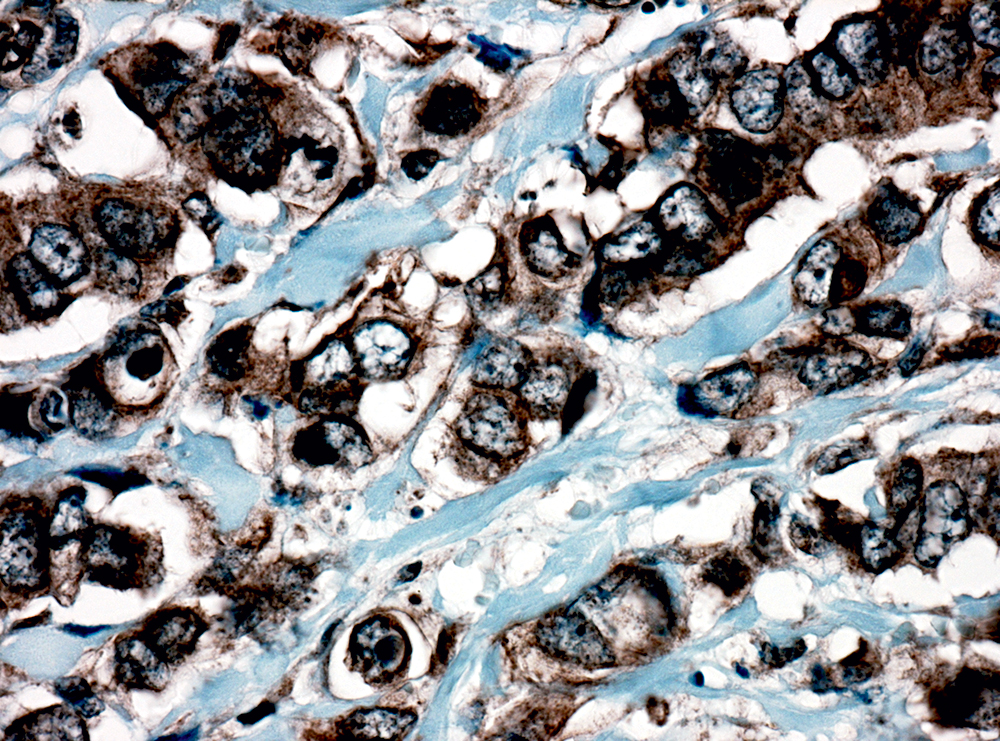
Anti-Catenin Delta 1 (P120)

Anti-Catenin Delta 1 (P120)
Catenins are proteins that are linked to cytoplasmic domain of transmembrane cadherins. P120 Catenin is a member of Armadillo gene family of junctional plaque proteins. The catenins forms association with cadherins, it results in a complex that is linked to the actin filament network. Cytoplasmic accumulation of p120 catenin has been observed in lung cancer, pancreatic cancer, gastric cancer and colon cancers and is associated with poor progress in colon cancer patients. In breast lobular neoplasia, anti p120 Catenin shows a diffuse cytoplasmic immunostaining pattern, while breast ductal neoplasma retains the membrane immunostaining pattern. P120 catenin antibody is useful in differentiation of lobular carcinoma from ductal carcinoma of the breast and in identifying early lesions of lobular neoplasia
| Intended Use | IVD |
|---|---|
| Antibody Type | Polyclonal |
| Clone | Polyclonal |
| Source | Rabbit |
| Tissue Type/Cancer Type | Breast Ca |
| Pack | 0.5 mL – Manual – Concentrate, 1 mL – Manual – Concentrate, 6 mL – Manual – RTU, 50 Tests – Automation – Xmatrx, 100 Tests – Automation – i6000, 160 Tests – Automation – Xmatrx, 5 slides – Xmatrx, 5 slides – Manual, 50 tests – NanoVIP® |